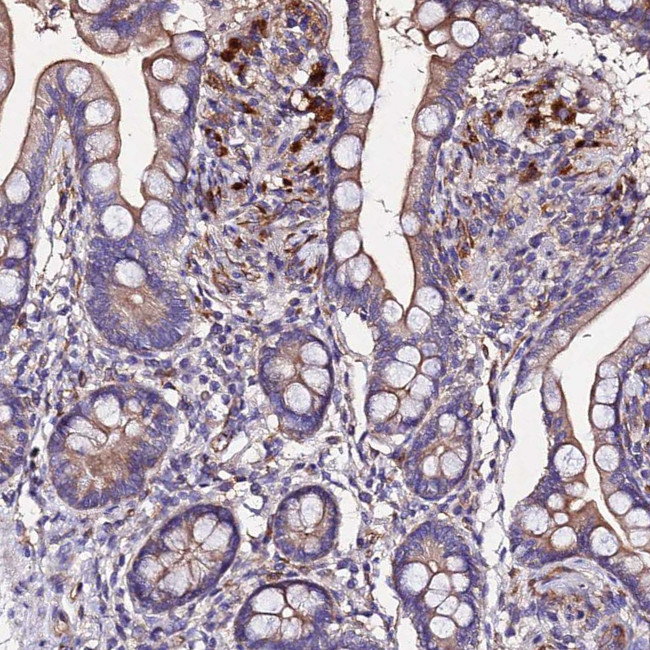
AP3M1 Antibody in Immunohistochemistry (Paraffin) (IHC (P))

Search
Invitrogen
AP3M1 Polyclonal Antibody
{{$productOrderCtrl.translations['antibody.pdp.commerceCard.promotion.promotions']}}
{{$productOrderCtrl.translations['antibody.pdp.commerceCard.promotion.viewpromo']}}
{{$productOrderCtrl.translations['antibody.pdp.commerceCard.promotion.promocode']}}: {{promo.promoCode}} {{promo.promoTitle}} {{promo.promoDescription}}. {{$productOrderCtrl.translations['antibody.pdp.commerceCard.promotion.learnmore']}}
产品信息
PA5-61040
种属反应
宿主/亚型
分类
类型
抗原
偶联物
形式
纯化类型
保存液
内含物
保存条件
运输条件
RRID
产品详细信息
Immunogen sequence: SGDIFLEKHW KSVVSQSVCD YFFEAQ
Highest antigen sequence identity to the following orthologs: Mouse - 100%, Rat - 100%.
靶标信息
The AP3 complex is a heterotetramer composed of two large adaptins (AP3D1, AP3B1 or AP3B2), a medium adaptin (AP3M1 or AP3M2) and a small adaptin (APS1 or AP3S2). The complex is associated with the Golgi region as well as more peripheral structures. It facilitates the budding of vesicles from the Golgi membrane and may be directly involved in trafficking to lysosomes. AP3M1 is highly homologous to AP3M2 but is the preferred binding partner to the YQRL motif from the cytosolic domain of TGN38. AP3M1 has also been shown to interact with the HIV-1 virulence protein Nef.
仅用于科研。不用于诊断过程。未经明确授权不得转售。
篇参考文献 (0)
生物信息学
蛋白别名: adapter-related protein complex 3 mu-1 subunit; adaptor related protein complex 3 mu 1 subunit; Adaptor-related protein complex 3 subunit mu-1; AP-3 adapter complex mu3A subunit; AP-3 adaptor complex mu3A subunit; AP-3 complex subunit mu-1; ap3; clathrin adaptor complex AP3, mu-3A subunit; Mu-adaptin 3A; Mu3A-adaptin; unnamed protein product
基因别名: AP3M1
UniProt ID: (Human) Q9Y2T2
Entrez Gene ID: (Human) 26985